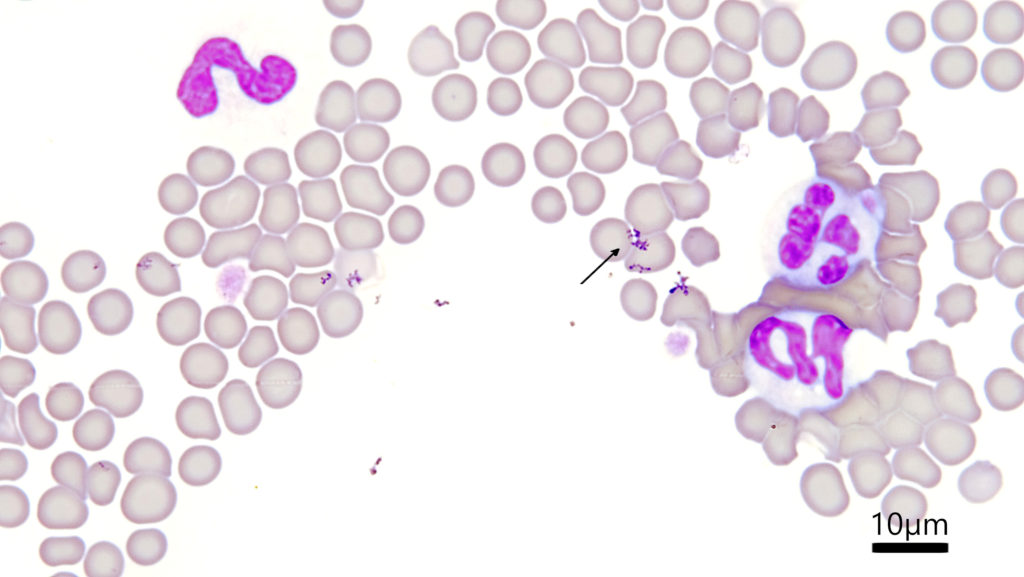

顕微鏡写真: アーティファクト 染色カス
先日、家で粉物の料理をしようとして密閉容器にしまってあった薄力粉をあけてびっくり。中に1-2mm程度の白い小さな小さな虫が10匹くらいうごめいていました、、、思わず写真も撮らずに捨ててしまいました。冷静になって思うと、顕微鏡で拡大してみたらどんな虫だったのか分かって今後の対策にもなったし、このブログの記事にもなったのになぁと。いや、冷静になって考えている発想がおかしいですね。密封容器に入れていたのにどこで混入したのだろうか。しばらくは薄力粉も片栗粉も容器を開けるのが怖いです。
さて、今月は久しぶりに塗抹のアーティファクトのご紹介です。なんだか今までも紹介していたような気がしていましたが、染色カスについてです。英語で言うとStain precipitateなのでそのまま訳すと染色の沈殿物、ということになりますが、染色カスという方がよく耳にするような気がします。早速写真をご覧いただきましょう。
この、血液の細胞とは一線を画すブツブツとしたものが染色カスです。血液塗抹の上に載っているような形なので、よくよく見るとピントが細胞たちとは少しずれたところに染色カスが存在しています。主に染色液が古くなっている場合や、染色後の洗浄が不十分だとこの染色カスが出やすくなります。赤血球表面に感染するマイコプラズマやその他の細菌感染と見間違えないように注意が必要です。

こちらは血液塗抹ではなく腹水の細胞診で得られた細菌の像ですが、細菌の方が染色カスより形が整っていて、観察対象の細胞と同じピントのところにあることがお分かりいただけるでしょうか。色も細菌の方が青っぽく、染色カスの方が紫が濃い印象です。あとは、細菌の方が少し大きく、染色カスの多くはサイズが結構小さいものが多いです。意外と染色カスか細菌かで相談を受けることが以前多かった覚えがあるので、皆様一緒によく確認してみましょう。


